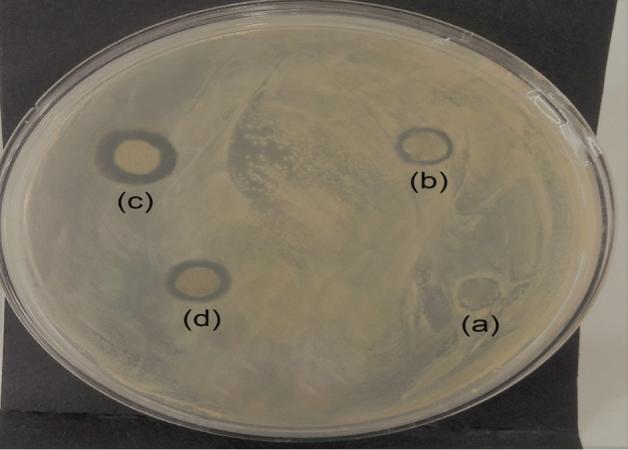
https://cdn.ncbi.nlm.nih.gov/pmc/blobs/e6ae/9244039/f9202222d1a3/289_2022_4311_Fig4_HTML.jpg
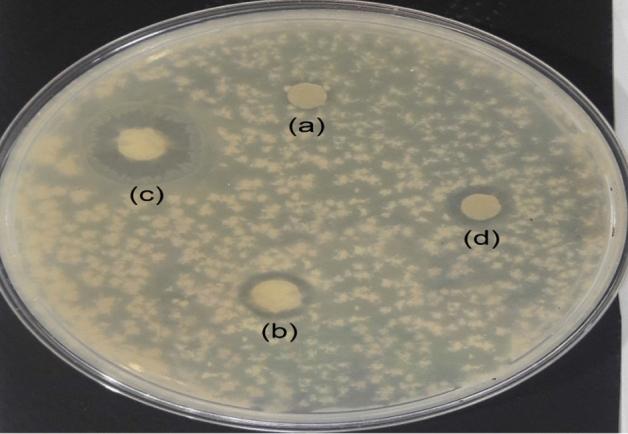
https://cdn.ncbi.nlm.nih.gov/pmc/blobs/e6ae/9244039/5d6dbd73bdc2/289_2022_4311_Fig5_HTML.jpg

用于空气过滤和抗菌活性的电纺聚丙烯腈/银纳米纤维膜的制备与评价
Fabrication and evaluation of electrospun polyacrylonitrile/silver nanofiber membranes for air filtration and antibacterial activity.
作者信息
Sohrabi Majid, Abbasi Marjan, Sadighzadeh Asghar
机构信息
Department of Textile Engineering, Faculty of Engineering, University of Guilan, Rasht, Iran.
Plasma Physics and Nuclear Fusion Research School, Nuclear Science and Technology Research Institute, AEOI, Tehran, Iran.
出版信息
Polym Bull (Berl). 2023;80(5):5481-5499. doi: 10.1007/s00289-022-04311-1. Epub 2022 Jun 29.
Particulate matter and airborne microorganisms are two of the most severe indoor air problems due to their significant risks to human health. Comprehensive research on air filtration with good filtration performance for fine particles and antibacterial function is essential. In this study, after some experimentations and optimization of conditions, polyacrylonitrile (PAN) 10-1% silver nanoparticles (AgNPs) membranes with suitable morphology and uniform diameter distribution are fabricated by an electrospinning method. These electrospun mats exhibited antibacterial activity toward (Gram-positive bacteria) and (Gram-negative bacteria). With its small pore size, high porosity, the high specific surface area of 42 m/g, and robust mechanical strength of 7.14 MPa properties, the resultant PAN10%-1%Ag membranes exhibit high filtration efficiency of 99.27%, the low pressure drop of 33 Pa, and higher quality factor compared to the two standard commercial masks including, the three-ply surgical mask and the respirator face mask. After 24 h of the filtration process in a simulated living environment, the obtained air filter still displayed a high filtration efficiency and a less pressure drop variation. In addition, the value was 0.99, which indicates that the calculation results are in good agreement with the measured results. The fabrication of PAN-Ag membranes will have broad applications, including face masks, indoor air filtration and clean room.
颗粒物和空气传播的微生物是两个最严重的室内空气问题,因为它们对人类健康有重大风险。对具有良好细颗粒过滤性能和抗菌功能的空气过滤进行全面研究至关重要。在本研究中,经过一些实验和条件优化,采用静电纺丝法制备了具有合适形态和均匀直径分布的聚丙烯腈(PAN)10%-1%银纳米颗粒(AgNPs)膜。这些静电纺丝垫对金黄色葡萄球菌(革兰氏阳性菌)和大肠杆菌(革兰氏阴性菌)表现出抗菌活性。所得的PAN10%-1%Ag膜具有小孔径、高孔隙率、42 m²/g的高比表面积和7.14 MPa的强大机械强度,与包括三层手术口罩和防毒面具在内的两种标准商用口罩相比,具有99.27%的高过滤效率、33 Pa的低压降和更高的品质因数。在模拟生活环境中进行24小时过滤过程后,所得空气过滤器仍显示出高过滤效率和较小的压降变化。此外,相关系数值为0.99,这表明计算结果与测量结果吻合良好。PAN-Ag膜的制备将有广泛的应用,包括口罩、室内空气过滤和洁净室。